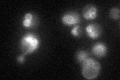
YML121W
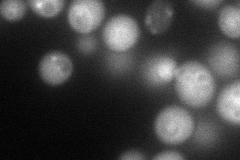
YML121W
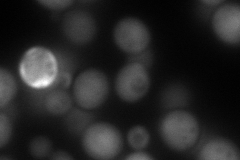
YML121W
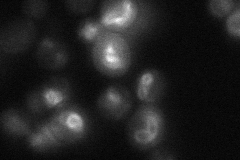
YML121W
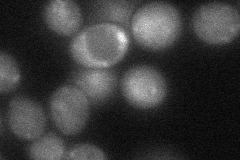
YML121W
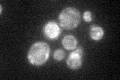
YML121W

View description
Cytoplasmic GTP binding protein and negative regulator of the Ran/Tc4 GTPase cycle; component of GSE complex, which is required for sorting of Gap1p; involved in phosphate transport and telomeric silencing; similar to human RagA and RagB
Localization:
Intensity:
Fold change:
Significance:
-
C’ GFP library in SD
vacuole membrane32.49 -
N' NOP1pr-GFP in SD
cytosol,vacuole membrane85.1549 -
N' TEF2pr-mCherry in SD
cytosol140.18 -
N' NATIVEpr-GFP in SD
vacuole membrane21.6253 -
N' TEF2pr-VC and Cyto-VN in SD
cytosol39.8367 -
C’ GFP library in SD+DTT

vacuole membrane35.111.08No -
C’ GFP library in SD+H2O2

vacuole membrane37.451.15No -
C’ GFP library in Starvation Media
vacuole membrane54.291.67Yes -
C’ GFP library on the background of Pup2-DaMP

vacuole membrane -
C’ GFP library on the background of CCT mutant

vacuole membrane33.05251.01718No
